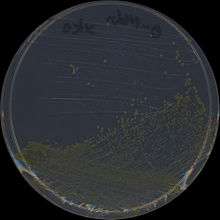
Colonies of the gram negative bacterium S. chlorophenolicum L1

Sphingobium chlorophenolicum
| Sphingobium chlorophenolicum | |
|---|---|
![]() | |
| Scientific classification | |
| Kingdom: | Bacteria |
| Phylum: | Proteobacteria |
| Class: | Alphaproteobacteria |
| Order: | Sphingomonadales |
| Family: | Sphingomonadaceae |
| Genus: | Sphingobium |
| Species: | S. chlorophenolicum |
| Binomial name | |
| Sphingobium chlorophenolicum | |
Sphingobium chlorophenolicum is a species of Proteobacteria.
Sphingobium chlorophenolicum strain L-1 is of interest to researchers because it can mineralize the toxic pesticide pentachlorophenol (PCP). [1] [2]
See also
References
- ↑ Copley SD; Rokicki J; Turner P; Daligault H; Nolan M; Land M. (2012). "The whole genome sequence of Sphingobium chlorophenolicum L-1: insights into the evolution of the pentachlorophenol degradation pathway.". Genome Biol Evol. 4 (2): 184–98. doi:10.1093/gbe/evr137. PMID 22179583.
- ↑ "Why sequence Sphingobium chlorophenolicum?". DOE Joint Genome Institute. Retrieved 7 February 2013.
External links
This article is issued from Wikipedia - version of the 9/29/2016. The text is available under the Creative Commons Attribution/Share Alike but additional terms may apply for the media files.